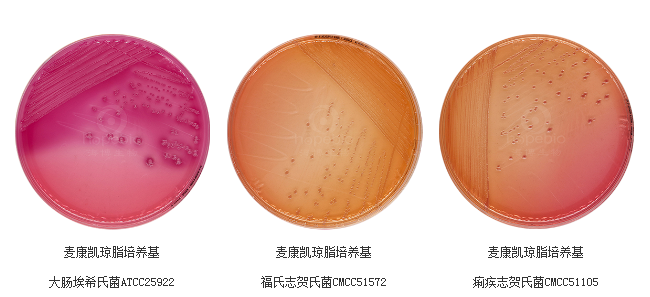
81712976.png 81712976.png

电话:13001385296
QQ:2105131983
办公:天津市武清区京滨工业园
产品名称:麦康凯琼脂
产品货号:HB6238
生产厂家:青岛海博
产品规格:250g / 瓶
保存条件:应储存于阴凉干燥处避光保存,防止受潮、结块和暴晒。
保质期:三年
产品用途:用于肠道致病菌的选择性分离培养。
产品成分:每升含蛋白胨20.0g,乳糖10.0g,3 号胆盐1.5g,氯化钠5.0g,中性红0.03g,结晶紫0.001g,琼脂15.0g,pH 值7.2±0.2(25℃)。
检验原理:利用胆盐和结晶紫抑制革兰氏阳性细菌的生长,同时结晶紫对部分革兰氏阴性菌如绿脓杆菌等也有一定抑制作用,从而选择性地促进革兰氏阴性肠道致病菌的生长。氯化钠维持培养基的渗透压。通过乳糖发酵,中性红的颜色变化可把分解乳糖和不分解乳糖的细菌区分开。志贺氏菌呈无色菌落,半透明,光滑,湿润,圆形,边缘整齐或不齐。乳糖发酵菌产生酸性物质,使菌落呈红色,非乳糖发酵菌菌落则呈无色。琼脂使培养基凝固,形成固体状态,便于细菌生长和观察。
使用方法:称取本品52.0g,加热溶解于1000ml蒸馏水中,121℃高压灭菌15分钟,备用。
麦康凯琼脂培养基上的细菌菌落特征:
麦康凯琼脂培养基微生物灵敏度试验:
按标签用法制备培养基,接种以下质控菌株,放置36±1℃需氧培养18-24小时。
注:回收率计算时,用TSA琼脂做对照培养基。
